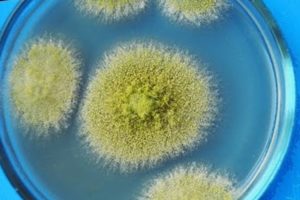

Введение
Онихомикоз, или грибковое поражение ногтей (фото 1), является наиболее распространенным заболеванием ногтей у взрослых и составляет одну треть всех грибковых инфекций кожи и до 50% всех заболеваний ногтей . Чаще всего поражаются ногти больших пальцев ног. В европейской и украинской популяции наиболее часто онихомикоз вызывают грибы-дерматофиты (Trihophyton); намного реже – плесневые грибы (Aspergillus niger и Candida) . Дерматофиты Trichophyton rubrum и Trichophyton mentagrophytes являются наиболее распространенными возбудителями онихомикоза – на них приходится до 90% всех случаев . Общая распространенность онихомикоза составляет около 14% всего населения. Мужчины страдают чаще женщин. Риск заражения увеличивается с возрастом: грибок обнаруживается у 15–20% лиц в возрасте от 40 до 60 лет, у 32% из пациентов в возрасте 60–70 лет, и у 48% лиц старше 70 лет. Последние данные свидетельствуют, что заболеваемость онихомикозом неуклонно растет . Некоторые заболевания ногтей (псориаз, атопический дерматит, травмы ногтя, контактные раздражители и красный плоский лишай – фото 2–3) могут имитировать онихомикоз, что представляет дополнительные трудности диагностики и требует обязательного лабораторного контроля до назначения лечения.
Предрасполагающими факторами в развитии онихомикоза являются:
- соматические заболевания: сахарный диабет, эндокринная патология, онкозаболевания, заболевания сосудов, ожирение;
- физиологические состояния: менопауза, гипергидроз;
- снижение местного иммунитета;
- нарушение питания ногтевого ложа (замедление скорости роста ногтя);
- физические факторы: механическое повреждение ногтя (травмы);
- химические факторы (постоянный контакт с водой, обезжиривающими моющими средствами).
Инфицирование грибком ногтя всегда вторично, то есть гриб предварительно поражает кожу стоп или рук, а только потом распространяется на ноготь. Здоровая ногтевая пластина является непроницаемой для гриба. Инфицирование ногтевого ложа происходит с краевых концов ногтя. Постепенно грибок распространяется под ногтевой пластиной, вплоть до матрикса ногтя.
Классификация онихомикозов (по Zaias N., 1972):
- дистальная форма онихомикоза – ноготь поражается с краев ногтевого ложа, ногтевая пластинка становится белесой, изменяется ее форма, ноготь становится неровным, крошится;
- поверхностная форма онихомикоза – на поверхности ногтя появляются белесые пятна, которые увеличиваются и через некоторое время поражают всю ногтевую пластину;
- проксимальная форма онихомикоза – ноготь поражается, начиная от ногтевого валика, затем область поражения распространяется на матрикс ногтя;
- тотальная дистрофическая форма они-хомикоза – ногтевая пластина неровная, утолщена, белесовато-желтого цвета с подногтевым гиперкератозом.
Диагностика и лечение
Диагностику и лечение грибковых заболеваний проводит дерматолог. Врач первым делом отправит вас сделать соскоб — чтобы определить вид грибка и назначить необходимое лечение. Причем те или иные медикаменты назначаются, исходя из общего состояния пациента, наличия или отсутствия других болезней. Поэтому самолечение неэффективно, а порой может даже ухудшить течение заболевания.
Основная опасность грибкового поражения ног заключается в том, что болезнь будет все время прогрессировать. Если грибок не лечить, то, начавшись на одном ногте, он перейдет на другие, а затем и на близлежащие участки кожи или ногти рук. В редких случаях встречается даже поражение внутренних органов.
Кроме того, возбудители данного заболевания, являясь очень сильными аллергенами, могут перестраивать чувствительность организма и тем самым вызывать различного рода аллергические реакции.
Многие больные предпочитают пользоваться широко рекламируемыми противогрибковыми лаками и мазями. Следует помнить, что противогрибковые лаки помогают только на первых стадиях заболевания и не действуют на всю толщу ногтя − во многих случаях необходим прием препаратов (таблеток) внутрь. Кроме того, некоторые из кремов действуют только на кожу, не проникая в ноготь. Эти средства предназначены в основном для профилактики.
Иногда люди не обращаются к врачам, опасаясь полного удаления ногтевой пластины. Этого не произойдет, так как метод удаления уже не применяется. В настоящее время используются мощные противогрибковые препараты, которые при правильном применении полностью избавляют от грибка.
В процессе лечения грибковой инфекции и после его окончания важно продезинфицировать все, с чем соприкасался грибок. Дезинфекции должны подвергаться полы, стены, инвентарь бань, душевых, ванных комнат, а также личные вещи больного: белье, обувь, предметы ухода за кожей и ногтями. Уменьшить риск заражения грибком можно при соблюдении следующих рекомендаций:
Уменьшить риск заражения грибком можно при соблюдении следующих рекомендаций:
- пользоваться индивидуальным полотенцем;
- носить индивидуальную домашнюю обувь;
- после бассейна обязательно принимать душ;
- не надевать в гостях тапочки;
- не примерять в магазине туфли на босую ногу.
Что покажет анализ крови и мочи при грибке ногтей
Самым высокоточным лабораторным методом выявления микозной инфекции считается ПЦР-тест. Данный анализ может определить, есть ли у вас грибок, при этом он эффективен как при острой форме инфекции, так и при хронической. Это современный способ выявления грибка, причем он срабатывает даже тогда, когда бактериологическая диагностика не показывает результата.
Высокая чувствительность данного метода и специфичность молекулярно-генетической экспертизы исключает возможность ложных результатов. Всего за несколько часов могут быть выявлены даже единичные споры и клетки патогенных микроорганизмов.
Виды грибков
Наиболее распространёнными возбудителями онихомикоза являются грибы-дерматофиты – около 86% всех случаев. Намного реже заболевание способны вызвать дрожжи и плесневые грибы. Может наблюдаться поражение ногтевой пластины, источником которого служат сразу 2 или 3 вида возбудителей.
Наиболее часто онихомитоз вызывается такими разновидностями микроорганизмов:
|
Проникновение дерматофитов в ноготь происходит чаще всего через боковую его часть, повреждённый стык кожи и ногтевой пластины. Этим микроорганизмам организм не в состоянии противостоять при пониженной работе иммунитета. Дерматофиты вызывают изменение структуры ногтя за счёт образования в нём полостей и каналов.
Плесневый грибок ногтей под микроскопом
Плесневый грибок ногтей под микроскопом
Поражение ногтей может быть вызвано и плесневыми грибами, но достаточно редко. При диагностике заболевания в этом случае возможно затруднение с определением возбудителя, так как характерные симптомы обычно отсутствуют. В данной ситуации может помочь лишь бактериологический анализ. Лечение онихомикоза, вызванного плесневыми грибами отличается от терапии поражения ногтей другими микроорганизмами.
Среди дрожжей онихомикоз чаще всего вызывают грибы Candida. В пределах нормы они содержатся на коже и слизистых оболочках каждого человека. Провоцирующим фактором для развития поражения ногтя дрожжевыми грибками также является ослабление иммунитета. Разрушение ногтя в результате деятельности таких микроорганизмов происходит от его основания, рядом с кутикулой.
Кто чаще всего подвержен заражению?
Возбудители онихомикоза небезопасны для каждого человека. Но особенно аккуратными необходимо быть тем, кто находится в группе потенциального риска инфицирования. Для таких людей регулярная профилактика ногтевого грибка должна стать повседневной работой.
Возглавляют список подверженных онихомикозу, лица, у которых этим заболеванием страдают родственники. Помимо основных профилактических мероприятий, специально для них существуют свои способы предупреждения инфекции, касающиеся круга отдельной семьи. В этот перечень входят следующие рекомендации:
- у больного должна быть собственная обувь, которую он носит дома и на улице;
- нельзя надевать любые предметы гардероба, человека, страдающего микозом;
- после принятия ванны за каждым членом семьи необходимо обрабатывать ее поверхность средствами дезинфекции.
Также грибковой инфекции ног подвержены лица, которые страдают следующими заболеваниями:
- варикозное расширение вен;
- плоскостопие и прочие деформации ступней;
- травмы ногтей — химические или физические;
- сахарный диабет.
 Наличие онихомикоза нельзя назвать приговором, так как патологию излечивают народными средствами и медикаментозными препаратами. Но всегда можно предотвратить заболевание. Профилактика грибка стопы основана на несложных правилах, соблюдать которые под силу каждому человеку.
Наличие онихомикоза нельзя назвать приговором, так как патологию излечивают народными средствами и медикаментозными препаратами. Но всегда можно предотвратить заболевание. Профилактика грибка стопы основана на несложных правилах, соблюдать которые под силу каждому человеку.
Что является причиной развития онихомикоза
Онихолитические поражения провоцируют патогенные грибки-дерматофиты. Они хорошо приспосабливаются к условиям среды, где обитают, а споры остаются жизнеспособными продолжительный срок — до нескольких месяцев.
Заразиться плесневыми или патогенными грибками возможно в:
- общественных раздевалках;
- бассейнах, саунах и публичных банях;
- спортивных залах и фитнес-клубах;
- общих душевых.
Микрофлора любит влажность и теплоту, споры активно размножаются. Их передача осуществляется при контакте ног с полом или зараженной обувью. Случается, что грибок заносят во время педикюра или маникюра.

Патология возникает из-за жизнедеятельности следующих микроорганизмов: Microsporum Canis, Epidermophyton Floccosum, Trichophyton. Самостоятельно заболевание не исчезает, в запущенных случаях можно полностью потерять ногтевую пластину. Онихомикоз провоцирует аллергию и постепенно отравляет организм.
Традиционные методы включают хирургическую операцию или терапию лекарственными препаратами. Перспективным способом лечения является лазеротерапия.
Грибок ногтей – что это такое?
 Запущенный грибок ногтя
Запущенный грибок ногтя
Онихомикозом называется грибковое поражение ногтевой пластины, вызываемое различными типами микроорганизмов, в основном, грибками-дерматофитами. Такие возбудители могут длительное время жить и размножаться в благоприятной для них среде. Заболевание заразно, по этой причине для его лечения обращаются как к дерматологам, так и к инфекционистам.
Чаще всего инфицирование происходит в общественных банях, саунах, бассейнах. Спровоцировать развитие грибкового поражения может и травмирование ногтевой пластины, вторичное иммунодефицитное состояние, нарушения в приёме антибиотиков.
На ранних стадиях развития заболевания имеют место следующие симптомы:
|
Обычно люди не обращают внимание на эти признаки. При отсутствии лечения происходит развитие грибкового поражения до запущенной стадии, когда микроорганизмы внедряются в ногтевую пластину и ведут свою жизнедеятельность уже под ней
На этом этапе избавиться от заболевания сложно, так как ноготь становится своеобразным «укрытием» грибков от воздействия местных медицинских препаратов.
Методы лечения грибка ногтей
На сегодняшний день существует несколько методов лечения данного заболевания:
- Медикаментозный метод. Такое лечение подразумевает прием системных противогрибковых препаратов. Вещества, содержащиеся в них проникают вглубь инфекции, губительно воздействуя на грибы. Но такой метод имеет много недостатков, самые явные из которых – множественные противопоказания, большая вероятность возникновения побочных эффектов и повышенная токсичность.
- Лечение местными препаратами. Данная методика основана на применении противогрибковых гелей, кремов, лаков или мазей. Но она отличается слабой эффективностью, ведь грибковая инфекция, поражая ногтевую пластину, устремляется вглубь тканей. А местная терапия воздействует только на поверхностные слои, поэтому такое лечение попросту бесполезно.
- Хирургический метод лечения. В таком случае хирургическим путем удаляется весь ноготь или его часть. Это достаточно действенная методика, однако тоже имеет некоторые недостатки. Такая процедура довольно болезненная и имеет продолжительный период реабилитации. К тому же новый ноготь может отрастать уже деформированным, что угнетает в эмоциональном и эстетическом плане.
- Метод лазерной терапии грибка ногтей. Данное лечение на сегодняшний день считается наиболее эффективным и самым безопасным. У него практически отсутствуют противопоказания и нет никаких побочных действий.
Многие пациенты, особенно женского пола, зачастую признаются, что отказываются от лечения потому, что стесняются идти к специалисту. Однако, следует признать, что повседневная жизнь настолько непредсказуема, что от такого заболевания не застрахован даже самый чистоплотный человек. Как показывает статистика, от грибка ногтей страдает практически каждый пятый житель мегаполиса
Поэтому крайне важно вовремя обратиться к врачу, пока заболевание находится на ранней стадии, чтобы остановить его прогресс и развитие серьезных осложнений
Чем же страшна запущенная болезнь? Такая инфекция довольно быстро распространяется и поражает здоровые ногти на руках и ногах. Если вовремя не обратиться за помощью к специалисту и не начать терапию, появляются следующие неприятные последствия:
- воспаление и сильная отечность ногтевого ложа;
- ощущение болезненности при прикосновении к пальцу;
- ноготь деформируется и отпадает;
- даже при потере ногтя инфекционный процесс не прекращается, оставаясь глубоко в кожных покровах и поражая заново отрастающие ногтевые пластины.
Помимо ощущения физического дискомфорта будут преследовать и эстетические неудобства. Повреждения ногтевых пластин приведет к тому, что открытая обувь будет под запретом, показывать на людях, пораженные грибком руки станет неудобно, путь в сауны и общественные бассейны также будет закрыт. К тому же близкие тоже находятся в зоне риска, общаясь с человеком у которого существует данная болезнь. Ведь грибок ногтей вполне может передаться и им .
Где цепляют грибок?
Список подобных мест бесконечен, поэтому перечислим те, где риск зацепить грибок наиболее высок:
- Дома, при использовании маникюрных принадлежностей «всей семьей» (одни ножницы или щипчики на всех, например).
- В салоне красоты (и дома) во время маникюра/педикюра, сеанса наращивания ногтей и т.д. при условии недостаточно качественной обработки инструментов.
- В бассейне — при хождении босиком возле самого бассейна или в общественных душевых.
- В общественных банях, саунах, тренажерных залах.
- При использовании общих полотенец.
- При использовании коврика для ванной «всей семьей».
- При ношении тугой или некачественной обуви.
- В СПА-салонах, фитнес-клубах.
- При «обмене» обуви (одна подружка дает поносить другой, или же гостям дают надеть тапочки кого-то из семьи).
- При частом использовании носков/колготок из синтетических волокон.
- При частом контакте (и последующем травмировании ногтевых пластин) с бытовой химией.
- При приеме оральных контрацептивов или антибиотиков.
Системная терапия
3 Опасность заболевания
Самостоятельный уход
- Содержите ногти короткими, сухими и чистыми. Используйте один клиппер для инфицированных ногтей, а другой – для обычных.
- Не просто лечите ногти; используйте противогрибковый крем для лечения кожи стопы.
- Избегайте обрезки кутикулы, самостоятельно или мастером маникюра, так как это увеличивает риск повреждения ногтей и их инфицирования.
Для грибковой инфекции на пальцах ног:
- Носите удобно облегающую обувь без высоких каблуков или узких носков.
- Содержите ноги сухими, носите хлопчатобумажные носки и меняйте их ежедневно, используйте «дышащую» обувь. Обычная стирка в горячей воде очищает большую часть зараженных носков, но ее можно сделать более эффективной, если перед стиркой использовать противогрибковый спрей. Другая одежда, как правило, не может быть заражена.
- Поддерживайте гигиену стопы, включая лечение любой инфекции.
- Носите чистую обувь для душа при использовании общего душа.
- Будьте особо внимательны в отношении гигиены пораженных стоп.
- Рассмотрите возможность обращения за помощью к ортопеду, если утолщенные ногти на ногах вызывают дискомфорт при ходьбе.
Эта статья была переведена из рекомендаций Британской ассоциации дерматологов «Обзорная информация для пациента», адаптирована на русский язык профессором Святенко Т.В., г. Днепр, Украина.
Будьте здоровы и привлекательны! Обращайтесь только к профессионалам. Используйте при изучении информации о вашей проблеме только данные доказательной медицины, такие, как приведены в этой статье.
Какой он – грибок ногтей
Одно из самых противных свойств микозов (разнообразных грибков) – обязательное их возвращение в случае, если лечение выбрано неправильно или приостановлено. Несмотря на все разнообразие микозов, которые различаются только симптоматикой и способами заражения, методика борьбы с этим заболеванием одна: комплексное воздействие на пораженные ногти и безусловное соблюдение личной гигиены (грибок – инфекционное заболевание).
Итак, как выглядит грибок ногтей? Приблизительно одновременно ноготь становится тусклым и, буквально, внешне нездоровым, хрупким и слоящимся. В большинстве случаев появляется пигментация белого, коричневого или желто-зеленого оттенка. Со временем, если не взяться за лечение, ноготь может начать разрушаться и крошиться, или, наоборот – появится его утолщение.

Все эти симптомы носят визуальный, характер и человек может самостоятельно поставить себе диагноз, но для назначения правильного курса лечения, необходимо, чтобы ситуацию оценил врач. Именно он сможет провести анализ истории появления, пронаблюдать динамику развития заболевания и объяснить, как вылечить грибок ногтей.
Какие анализы сдают для выявления грибка ногтей
Существует несколько способов определения типа грибковой инфекции. В медицинских лабораториях исследование материала проводят одним из ниже перечисленных методов:
- Соскоб на грибок ногтей – один из наиболее популярных методов диагностики. Процедура предполагает изъятие специалистом фрагмента поражённого ногтя. Выбранный участок должен иметь явные признаки грибкового поражения. Соскоб помогает определить, что вызвало повреждение ногтевой пластины – грибок, либо другой вредоносный микроорганизм.
- Посев. Анализ помогает определить не только тип заболевания, но штамм грибка, вызвавший поражение ногтя. Фрагмент патологической ткани помещают в ёмкость с питательной средой. Лаборант наблюдает за пробиркой, чтобы понять, какая культура грибка развивается активнее. Определение вида микроорганизма позволяет правильно назначить лечение, выбрать препарат.
- ПЦР-диагностика. Для этого анализа достаточно сдать кровь. Специалист определит ДНК патологического микроорганизма. Анализ даёт возможность обнаружить грибок и определить его штамм. Данный тип диагностики позволяет обнаружить заболевание даже на начальном этапе развития.
- Биохимический анализ крови на грибок помогает определить стадию заболевания.
Бывает, что результат анализа оказывается отрицательным. Тогда специалист рекомендует пройти полную диагностику.
Анализ обязательно сдают и после окончания лечения, чтобы убедиться, что инфекция побеждена. Терапию продолжают до тех пор, пока тест не покажет отрицательный результат дважды с интервалом в 2 недели.

Стадии грибка ногтей на ногах и руках
Диагностика
Для подтверждения диагноза специалист выдает пациенту направление на анализы:
- Микроскопия. Соскоб, снятый с ногтевой пластины, лаборант обрабатывает особым веществом для разрушения кератина. В таком виде материал легче поддается исследованию под микроскопом. Недостатком микроскопического исследования является невозможность определения типа грибка. Однако ответы анализа уже служат основанием для назначения антимикотиков широкого спектра действия.
- Культуральное исследование. В лабораторных условиях материал помещают в питательную среду Сабуро – посев для быстрого развития грибка. Возбудителя идентифицируют по цвету, скорости роста и форме колоний паразита. Также методика выявляет чувствительность штаммов к медикаментозным препаратам. Но результаты анализа пациент получает только через 3 – 5 дней после его проведения.
- ДНК-диагностика. Обнаружение ДНК-клеток грибковой инфекции происходит при изучении соскоба ногтя, пораженного дерматофитами или кандидозными грибками. Плесневые штаммы метод не определяет. Результаты анализа больному выдают в течение 1 – 2 дней. Недостатком ДНК-диагностики онихомикоза стоп является высокая стоимость, обусловленная необходимостью применения специальной аппаратуры.
Внешние симптомы грибка не специфичны, они лишь указывают на поражение ногтей на ногах. Причина заболевания становится понятной только после проведения диагностических исследований. Для назначения адекватной терапии онихомикоз стоп дифференцируют от красного плоского лишая, псориаза ногтей, кератодермии и других заболеваний, вызывающих нарушение питания ногтей.
Лечение грибка ногтей лазером
Лазерное лечение грибка ногтей – это щадящая процедура, она позволяет полностью удалить ногтевую пластину без разрезов ткани. Подобный вид терапии эффективно используется в современной медицинской практике, позволяет комфортно провести терапию грибковых заболеваний.
Особенность лечения грибка лазером
Лазер представляет собой специальное устройство, генерирующее электромагнитные волны в виде ультратонких пучков интенсивного света. Свет проникает в глубину ногтя вплоть до 7 мм, полностью выжигает мицелий грибка. К проведению процедуры необходимо подготовиться:
- За неделю до терапии отмените прием противогрибковых препаратов.
- Накануне распарьте ногти в горячей воде. Для этого приготовьте раствор из пяти литров горячей воды, 25 г пищевой соды и 50 г хозяйственного мыла. Держите ноги в воде не менее 20 минут.
- Подстригите ногти как можно короче.
- За два дня до диагностики снимите лак, либо любое другое покрытие.
- Откажитесь на время от использования кремов, дезодорантов, и прочих ухаживающих средств.
Процедура лазерной терапии проводится следующим образом:
- надеваются специальные очки, чтобы защитить глаза от излучения;
- производится обработка пораженного ногтя посредством антисептического раствора;
- наносится особый гель;
- в зависимости от степени поражения и распространения инфекции лазерная процедура занимает по времени от 10 до 30 минут;
- в конце процедуры устраняются остатки геля.
Помимо этого в частной клинике могут предложить произвести дезинфекцию носков и обуви с помощью озона. Не отказывайтесь от подобной услуги, так как с помощью такой процедуры вы уберете оставшиеся грибковые споры и предотвратит возможный рецидив заболевания.
Виды лазерной терапии
Для того чтобы провести удаление грибка ногтей лазером применяют несколько типов лазеров, они оказывают различное воздействие на пораженный участок, отличаются по длине волн:
Пенсионеры! Не стригите грибковые ногти! Они выводятся просто: возьмите 9 гр…
Военврач: Чтобы у солдат не было грибка, они 2 раза в день…
- Неодимовый. Действует на ноготь фототермически, нагревая пораженную ткань до 43-52 градусов. При этом кожный покров не нарушается, процедура проходит бескровно и безболезненно. Световая волна проникает глубоко в ноготь, разрушает причину заболевания – мицелий (грибницу). Также неодимовый лазер отличается антибактериальным, заживляющим эффектом. Он позволяет клеткам быстро восстанавливаться. Для полного выздоровления достаточно пяти-семи процедур.
- Диодный. Такой тип лазера оказывает тепловое воздействие на ноготь. Такой процесс в медицинской практике носит название – абляция, когда поврежденные, инфицированные ткани испаряются под лучом. При этом здоровые клетки остаются нетронутыми. Такое лазерное удаление грибка проводится бескровно, но пациент может ощущать легкое покалывание или жжение. Количество сеансов зависит от степени поражения и места расположения грибка.
- Эрбиевый. Действует на ноготь безболезненно, показывает на ткань термическое и абляционное воздействие, испаряя все слои грибка. Такое излучение не вызывает ожогов, сразу удаляет сосуды, которые питают грибницу грибка. Эрбиевый луч более бережный, нежели диодный, но ногтевая пластина также подвергается разрушению. С помощью такого лазера можно проводить работы в самых труднодоступных местах. Для полного выздоровления достаточно пяти-шести сеансов.
Куда обратиться за услугой?
Для удаления грибка лазером вы можете обратиться в медицинский центр. Бывают случаи, когда в салонах красоты также предоставляется услуга по лечению ногтей посредством лазера. Хотя далеко не все мастера являются дипломированными специалистами. Поэтому перед проведением процедуры узнайте, сколько стоит лечение онихомикоза посредством лазеротерапии и можно ли доверять мастеру проведение подобных процедур.
Помимо этого вы можете обратиться в местный районный центр. Цена за процедуру в среднем будет составлять от 20 до 25 долларов. В частной клинике стоимость может возрастать до 80 долларов
Важно уточнить возможность проведения процедуры по месту жительства
Как выглядят грибковые инфекции ногтей?
Поражение ногтя грибком обычно начинаются с его свободного края, а затем распространяется по стороне ногтя к основанию кутикулы. В конце концов может быть поражен весь ноготь. Зараженные области становятся белыми или желтоватыми, становятся утолщенными и слоящимися. Реже на поверхности ногтя могут быть белые включения. Наиболее подвержены повреждению грибковыми инфекциями ногти на больших пальцах ног и мизинцах. Иногда, особенно у тех, кто регулярно проводит влажную работу, например, у домохозяйки или уборщицы, кожа вокруг ногтя становится красной и опухшей. Это называется паронихией и может позволить инфекции легко попасть в ноготь.
Симптомы грибка ногтей на руках
Как можно лечить грибковые инфекции ногтей?
Грибковые инфекции ногтя сами по себе не беспокоят, не все из них нуждаются в лечении. Некоторые люди с инфицированными ногтями на ногах не беспокоятся о них вообще. В этом случае их иногда можно оставить в покое (хотя пациент должен оставаться осторожным и стараться не распространять инфекцию на другие части тела и ногти, а также других людей).
С другой стороны, если инфицированные ногти приносят неловкость или неудобство, их обычно лечат
Важно лечить людей, чьи инфекции могут вызвать серьезные проблемы со здоровьем, такие как диабет или снижение иммунитета, чтобы предотвратить потенциально серьезные проблемы со здоровьем
Цель лечения – избавиться от грибка: тогда ноготь обычно возвращается к нормальному состоянию. Однако, если ноготь был поврежден, прежде чем он был заражен, его будет труднее очистить и он может вернуться в прежнее состояние. Инфекции ногтей, вызванные плесенью и дрожжами, могут быть очень устойчивыми к лечению.
Установление диагноза
Прежде чем провести лечение онихомикоза, нужно провести лабораторные исследования:
- Соскоб на грибок – роговые массы или кусочек ногтя помещают в раствор, который разрушает кератин, затем изучают их под микроскопом. Это исследование помогает определить инфекцию, но не вид грибка;
- Бакпосев проводят для выявления типа грибка. Биоматериал помещают в питательную среду, затем под микроскопом изучаются выросшие культуры;
- ДНК диагностика онихомикоза позволяет определить тип возбудителя.
После анализов миколог или дерматолог составляет схему лечения.
Диагностика позволит отличить микозы от негрибкового поражения ногтей на ногах.
Диагностика для определения заболевания
Какой врач лечит онихомикоз
При первых проявлениях грибка на пальцах ног (онихомикозе), к которым относятся: покраснение, зуд между пальцами, изменение цвета ногтевой пластины, необходимо в экстренном порядке обращаться за помощью. К какому врачу? Для того чтобы получить квалифицированную помощь и лечение нужно знать к какому врачу идти с грибком ногтей. Есть два варианта выбора, которые зависят от доступности приема врача. На начальной стадии заболевания для диагностики рекомендуется обратиться в ближайшую поликлинику к дерматологу, который ведет бесплатный прием.
Миколог
Врач миколог это тот же дерматолог, который специализируется по более узкому профилю. Этот врач, который лечит грибок ногтей на ногах, коже и волосах. Но найти врача по данному медицинскому направлению найти очень сложно. Обычно они работают в крупных клиниках в мегаполисах. В небольших городках доктор миколог встречается очень редко, зато, если посчастливится его найти, то узкопрофильный специалист поможет вылечить грибковое заболевание быстро и качественно.
Дерматолог
Медицинский сотрудник, который занимается лечением всех проблем с кожными покровами, в том числе и с грибковыми заболеваниями ногтей на ногах. Профиль работы позволяет врачу дерматологу лечить кожные заболевания вирусного и инфекционного типа, таких как:
- экзема,
- дерматиты,
- воспаления,
- сыпи,
- заболевания, вызванные грибковыми возбудителями.
Дерматологи принимают в любой поликлинике и кожно-венерологическом диспансере. Если не знаете, к какому врачу обратиться с грибком, то для первичного обследования подойдет любой дерматолог. Если болезнь не запущена, дерматолог может сам назначить лечение, но в тяжелых случаях он даст направление к микологу для более квалифицированной консультации и глубокого лечения.
К какому лучше обратиться
Узкопрофильный специалист поможет вылечить грибковое заболевание быстро
Если появилось подозрение на грибок ногтей, к какому врачу обратиться? Естественно к микологу. Это врач, который занимается именно лечением грибка и знает все особенности этого вида микроорганизмов. Миколог назначает лекарство от грибка стопы, даёт назначения по грибку ногтей, занимается профилактикой заболеваний, которые связанны именно с микозами. Многие дерматологи не имеют необходимых знаний для глубокого понимания проблемы, связанной с грибком стопы и ногтей на ногах.
В компетенцию миколога входит:
- лечение и профилактика возникновенич грибковых и негрибковых заболеваний кожи, волос и ногтей. К проблемам негрибкового характера относятся: изменение цвета ногтевой пластины его формы, ушибы ногтевых пластин, омозолелости. Онихомикоз, кандидоз, эпидермофития, микроспория, трихофития — заболевания грибкового характера, потому что их вызывают плесневые или дрожжевые грибки;
- проведение лабораторных анализов и расшифровка результатов.
Показания к анализу на грибок
Первыми симптомами грибковой инфекции являются зуд, трещины и шелушение на коже, а также слоение ногтевой пластины. При возникновении этих признаков дерматолог пошлёт пациента на микробиологическое исследование.
Показаниями к проведению анализа на грибок являются следующие симптомы:
- подозрение на наличие грибковой инфекции кожи, волос или ногтей;
- изменения структуры ногтя;
- потемнение пластины;
- зуд и шелушение кожного покрова вокруг ногтя;
- изменение цвета или утолщение ногтевой пластины;
- крошение ногтей;
- воспаление и покраснение кожного покрова в очаге поражения.
Если анализ подтвердит диагноз онихомикоз, дерматолог назначит соответствующее лечение.
Описание и способы применения препаратов
Серьёзный подход – залог успешного лечения грибка в запущенной форме. Пациенты, которые регулярно используют прописанные врачом препараты без пропуска в их применении, добиваются наилучших результатов. При несоблюдении врачебных рекомендаций грибок может приобрести устойчивость к лекарствам и придётся подбирать новые медикаменты, что приведёт к дополнительным сложностям.
Общие правила для применения препаратов:
|
Как берется материал для исследования

Анализ методом посева на грибок ногтей
Материал для исследования берет специалиста с помощью специального инструмента. Выбирают обычно часть ногтя, которая имеет на себе признаки поражения грибком. Это затемненные или обесцвеченные участки. При расслоении ногтей берут одну или две чешуйки.
Иногда имеет смысл взять элемент дермы с воспалившегося приногтевого валика. Взятый патологический материал измельчают, и только после этого исследуют. В первую очередь осматривают его под микроскопом, а потом помещают в отдельные баночки для более подробного анализа. Для нескольких видов исследования материал берется один раз.
Крайне важно брать забор материала в перчатках






























